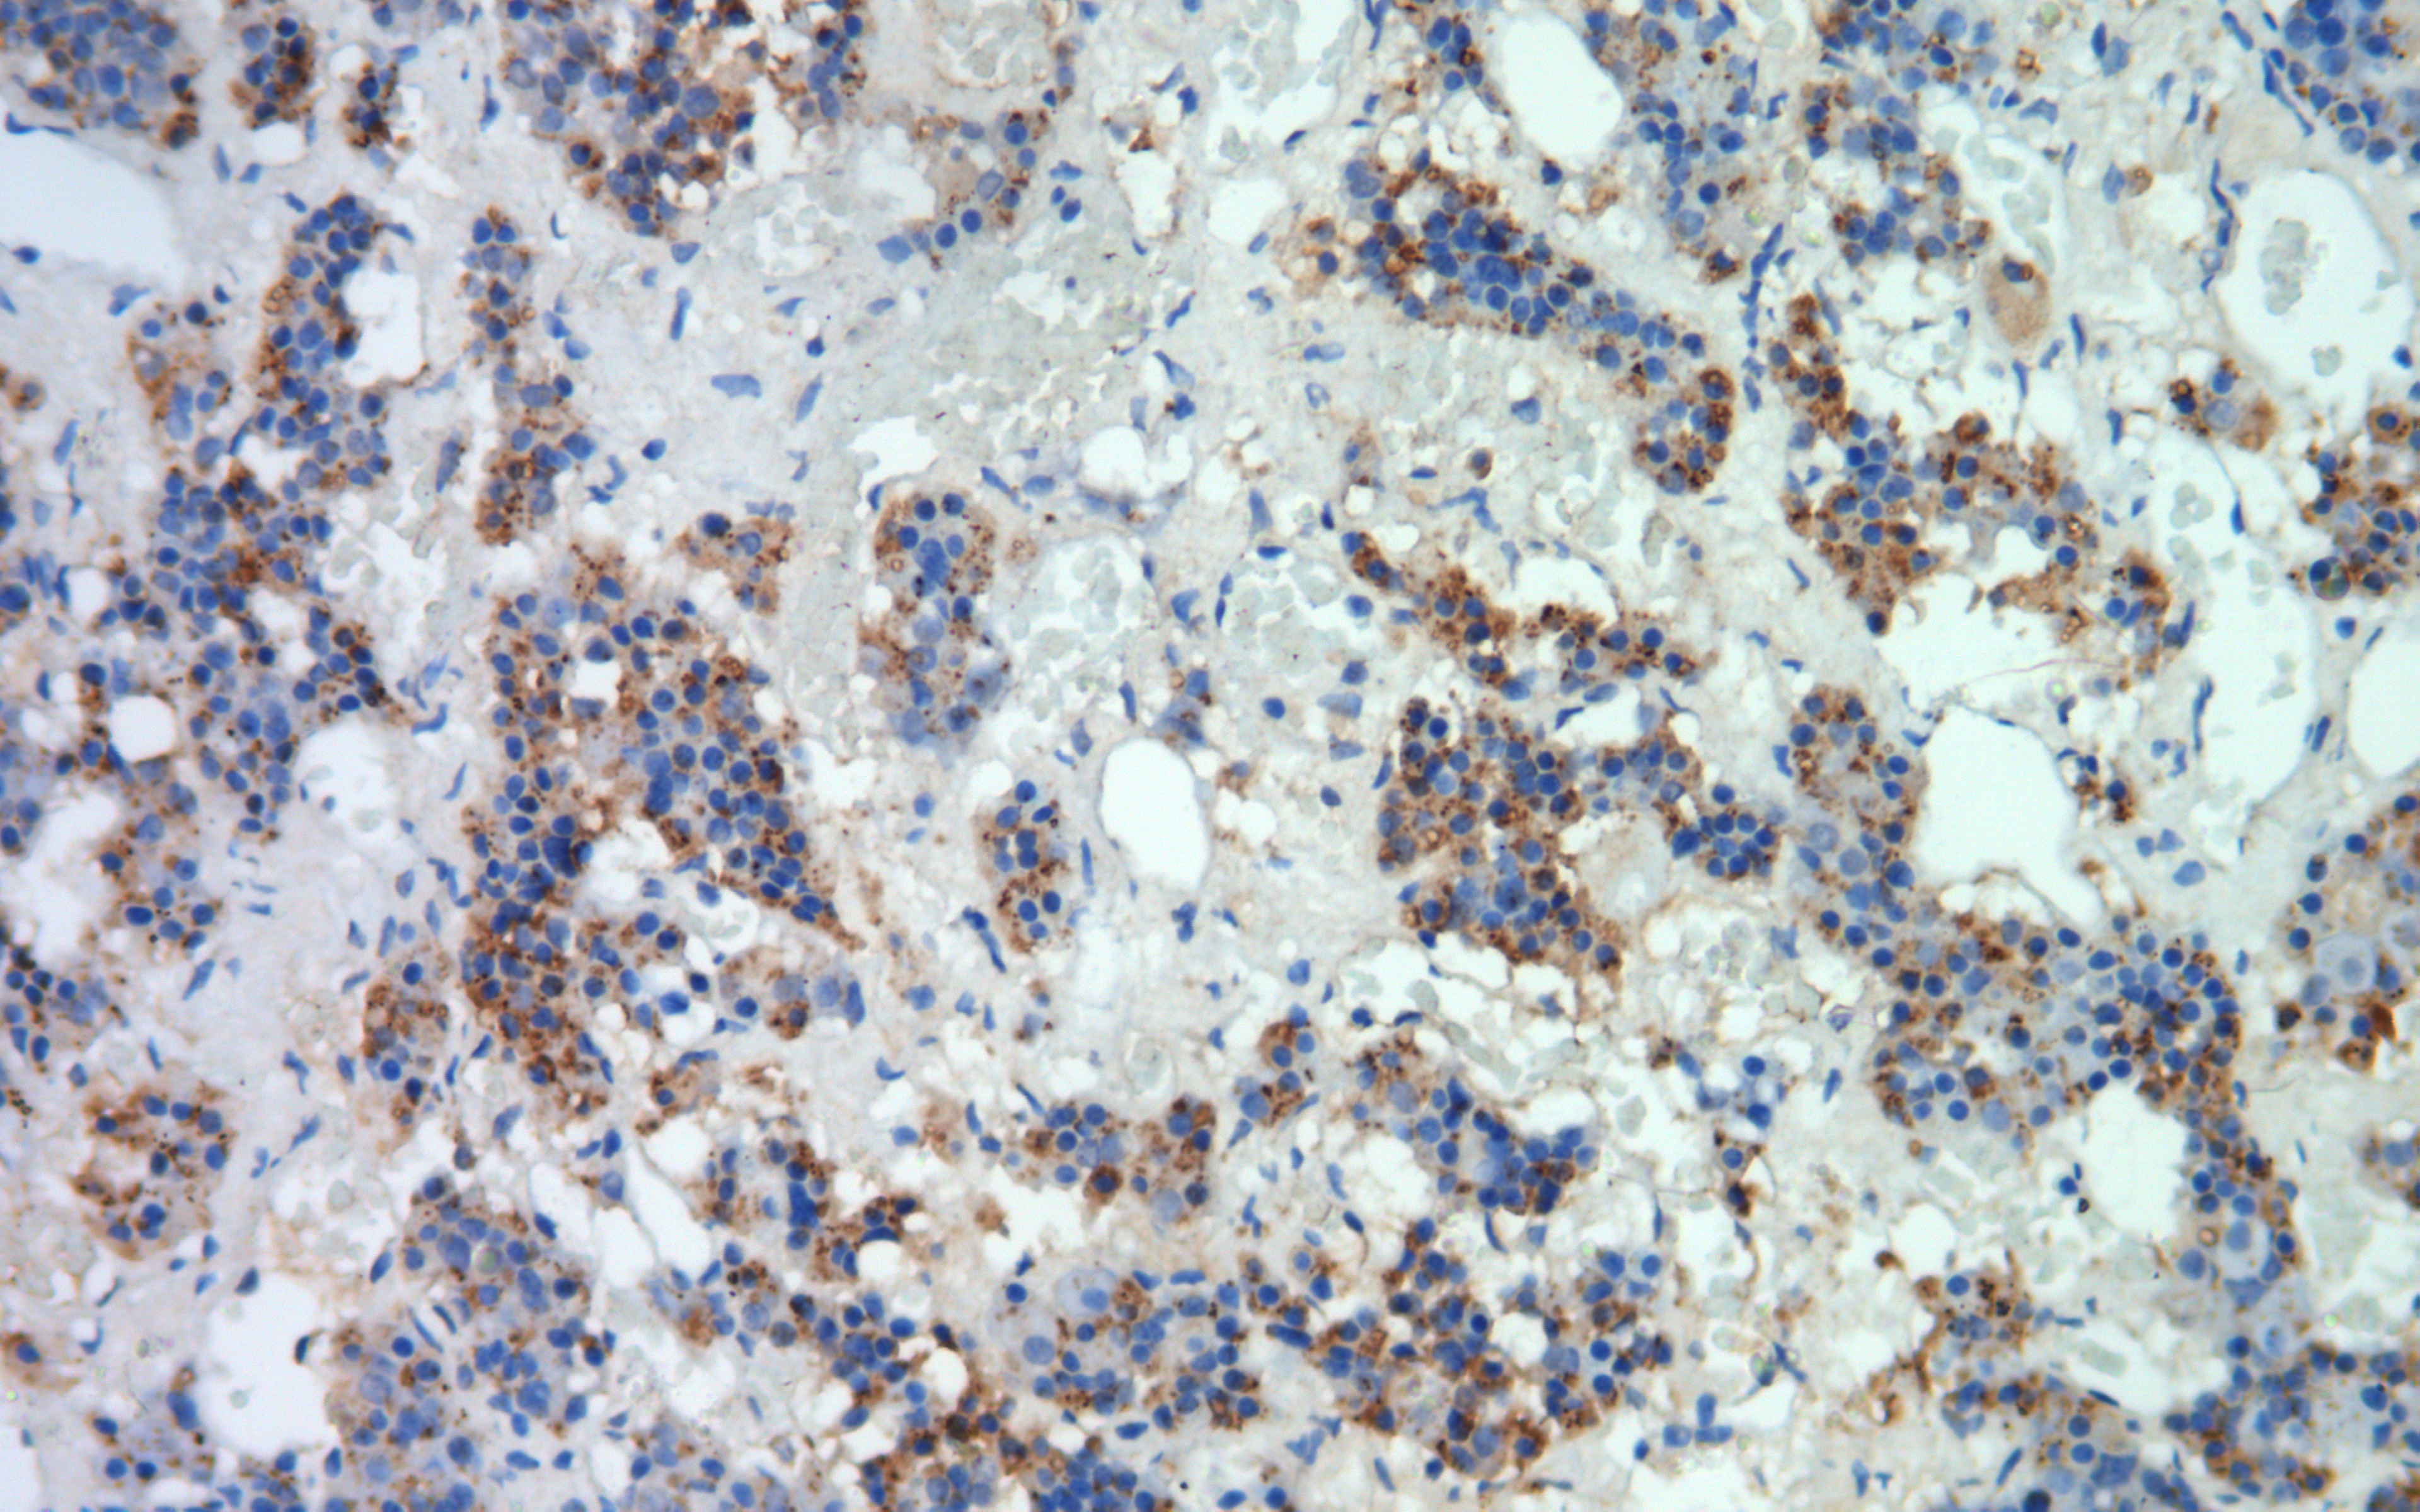

FSH
Mouse Monoclonal antibody(Mab)
- SPECIFICATION
- CITATIONS
- PROTOCOLS
- BACKGROUND

Application
| IHC-P |
|---|---|
| Primary Accession | P23945 |
| Reactivity | Human |
| Host | Mouse |
| Clonality | Monoclonal |
| Clone Names | 265F3G3 |
| Calculated MW | 78238 Da |
| Gene ID | 2492 |
|---|---|
| Gene Name | FSHR |
| Other Names | Follicle-stimulating hormone receptor, FSH-R, Follitropin receptor, FSHR, LGR1 |
| Dilution | IHC-P~~Ready-to-use |
| Storage | Maintain refrigerated at 2-8°C |
| Precautions | FSH Antibody is for research use only and not for use in diagnostic or therapeutic procedures. |
| Name | FSHR |
|---|---|
| Synonyms | LGR1 |
| Function | G protein-coupled receptor for follitropin, the follicle-stimulating hormone (PubMed:11847099, PubMed:24058690, PubMed:24692546). Through cAMP production activates the downstream PI3K-AKT and ERK1/ERK2 signaling pathways (PubMed:24058690). |
| Cellular Location | Cell membrane; Multi-pass membrane protein |
| Tissue Location | Sertoli cells and ovarian granulosa cells. |

Thousands of laboratories across the world have published research that depended on the performance of antibodies from Abcepta to advance their research. Check out links to articles that cite our products in major peer-reviewed journals, organized by research category.
info@abcepta.com, and receive a free "I Love Antibodies" mug.
Provided below are standard protocols that you may find useful for product applications.
If you have used an Abcepta product and would like to share how it has performed, please click on the "Submit Review" button and provide the requested information. Our staff will examine and post your review and contact you if needed.
If you have any additional inquiries please email technical services at tech@abcepta.com.













 Foundational characteristics of cancer include proliferation, angiogenesis, migration, evasion of apoptosis, and cellular immortality. Find key markers for these cellular processes and antibodies to detect them.
Foundational characteristics of cancer include proliferation, angiogenesis, migration, evasion of apoptosis, and cellular immortality. Find key markers for these cellular processes and antibodies to detect them. The SUMOplot™ Analysis Program predicts and scores sumoylation sites in your protein. SUMOylation is a post-translational modification involved in various cellular processes, such as nuclear-cytosolic transport, transcriptional regulation, apoptosis, protein stability, response to stress, and progression through the cell cycle.
The SUMOplot™ Analysis Program predicts and scores sumoylation sites in your protein. SUMOylation is a post-translational modification involved in various cellular processes, such as nuclear-cytosolic transport, transcriptional regulation, apoptosis, protein stability, response to stress, and progression through the cell cycle. The Autophagy Receptor Motif Plotter predicts and scores autophagy receptor binding sites in your protein. Identifying proteins connected to this pathway is critical to understanding the role of autophagy in physiological as well as pathological processes such as development, differentiation, neurodegenerative diseases, stress, infection, and cancer.
The Autophagy Receptor Motif Plotter predicts and scores autophagy receptor binding sites in your protein. Identifying proteins connected to this pathway is critical to understanding the role of autophagy in physiological as well as pathological processes such as development, differentiation, neurodegenerative diseases, stress, infection, and cancer.